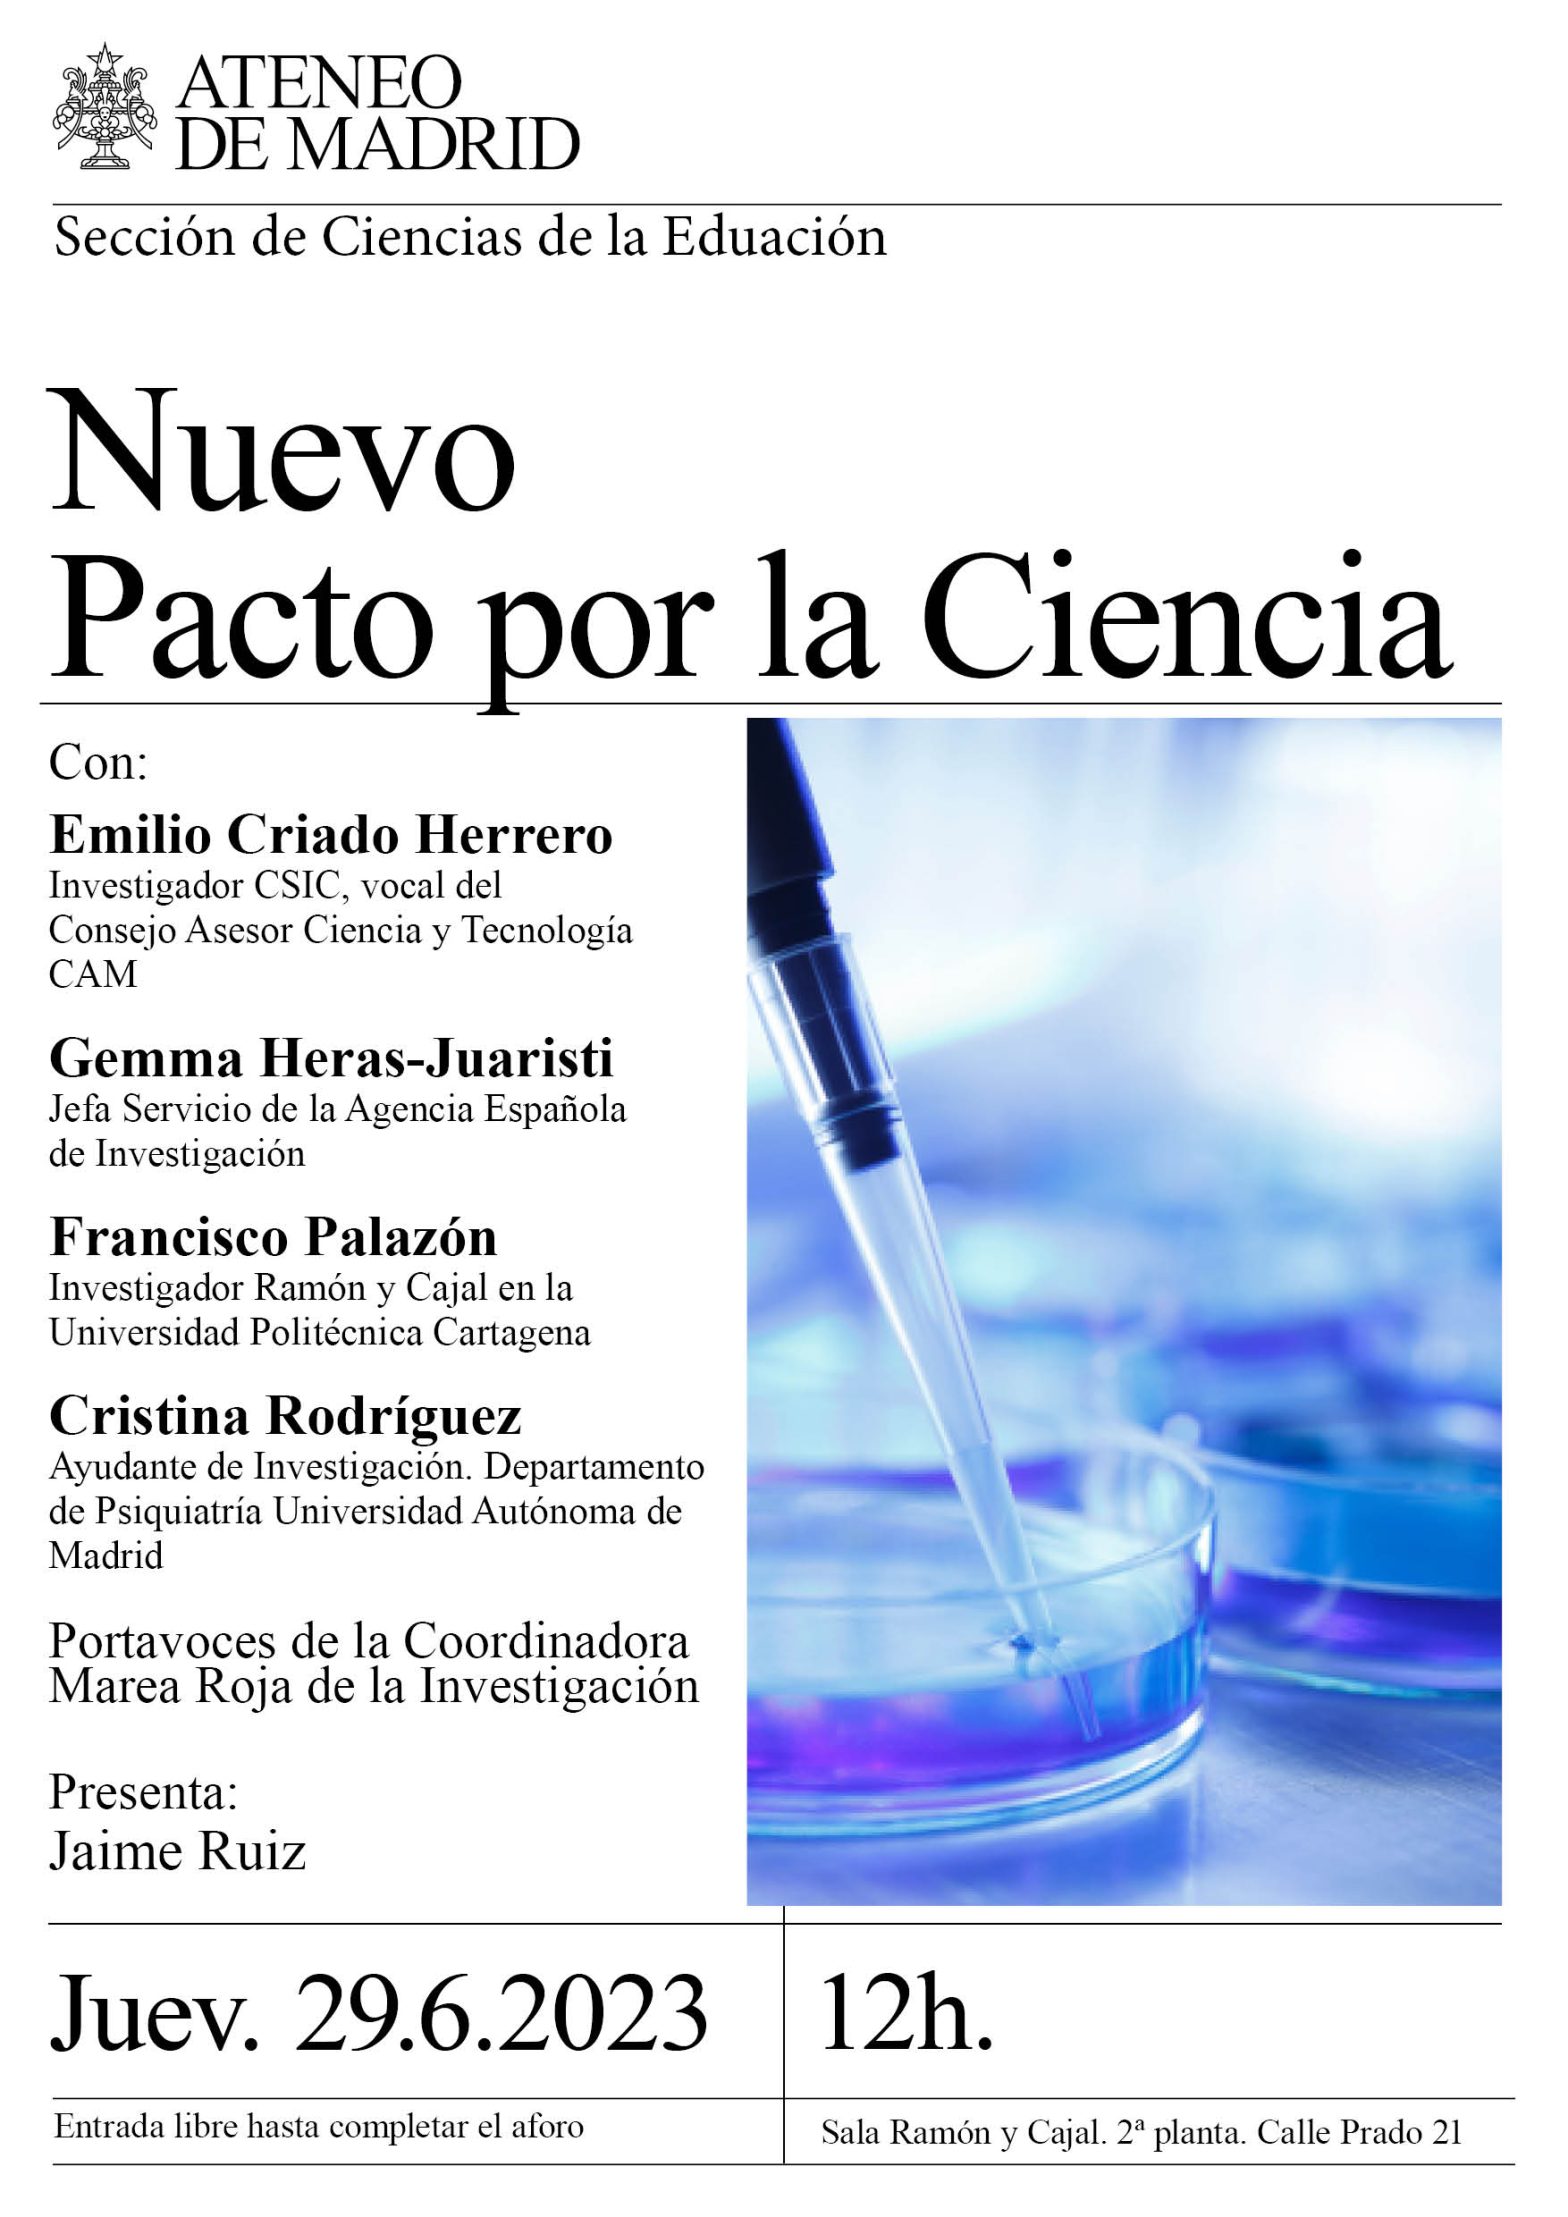

- Este evento ha pasado.
Nuevo Pacto por la Ciencia


Sección Ciencias de la Educación. Sala Ramón y Cajal. 12h.
Con motivo de las próximas elecciones generales el colectivo Marea Roja de la investigación, integradas por asociaciones, sindicatos y sociedades científicas del ámbito de la investigación, han promovido la firma de un documento denominado Nuevo Pacto por la Ciencia, que reivindica el papel central de la ciencia y la cultura científica en la creación de una sociedad mas activa y responsable ante el peso del sistema científico técnico en la conformación y valores de nuestra sociedad
El documento ha sido firmado por una treintena de asociaciones y por los partidos políticos mas relevantes en nuestra comunidad.